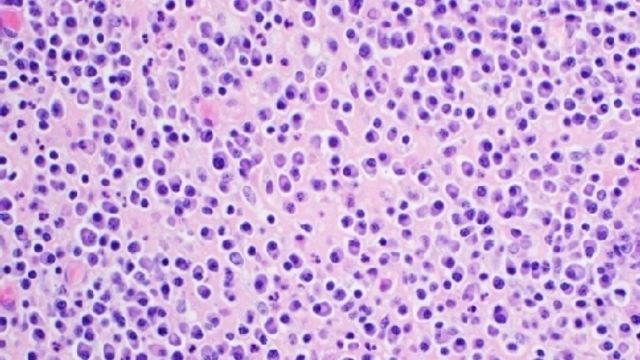

Una nuova terapia sperimentata in Italia raddoppia la sopravvivenza di pazienti affetti da mieloma multiplo. E' basata sull'introduzione di nuovi farmaci, come talidomide, lenaldiomide e bortezomib, e il trapianto di midollo osseo autologo. Il risultato è emerso da uno studio dell'Ospedale Molinette e dell'Università di Torino, pubblicato su The New England Journal of Medicine.
Lo studio - Il mieloma multiplo è il secondo tumore ematologico più frequente e colpisce in particolare l'anziano. L'età media alla diagnosi è infatti di 70 anni. Lo studio coordinato dal team di Torino ha preso in considerazione 1.623 pazienti in 18 Paesi del mondo.
Duplice approccio - I risultati emersi dimostrano come il trapianto debba essere adottato subito alla diagnosi, e non posticipato nel tempo. Inoltre, la somministrazione di una terapia di mantenimento dopo il trapianto ha ulteriormente migliorato il beneficio clinico indotto dal trapianto. Un approccio sequenziale, che comprende sia il trapianto che il mantenimento con lenalidomide, sembra dunque essere una strategia ottimale in questi pazienti.
Trattamento continuativo - Antonio Palumbo, a guida dello studio, spiega: "Un trattamento continuativo è fondamentale nel mieloma multiplo. Infatti, se si sospende la terapia, la patologia si ripresenta, a causa della presenza di malattia residua. Con un trattamento continuo, invece, si ritarda la ricrescita del tumore. Una terapia che in precedenza non era possibile".